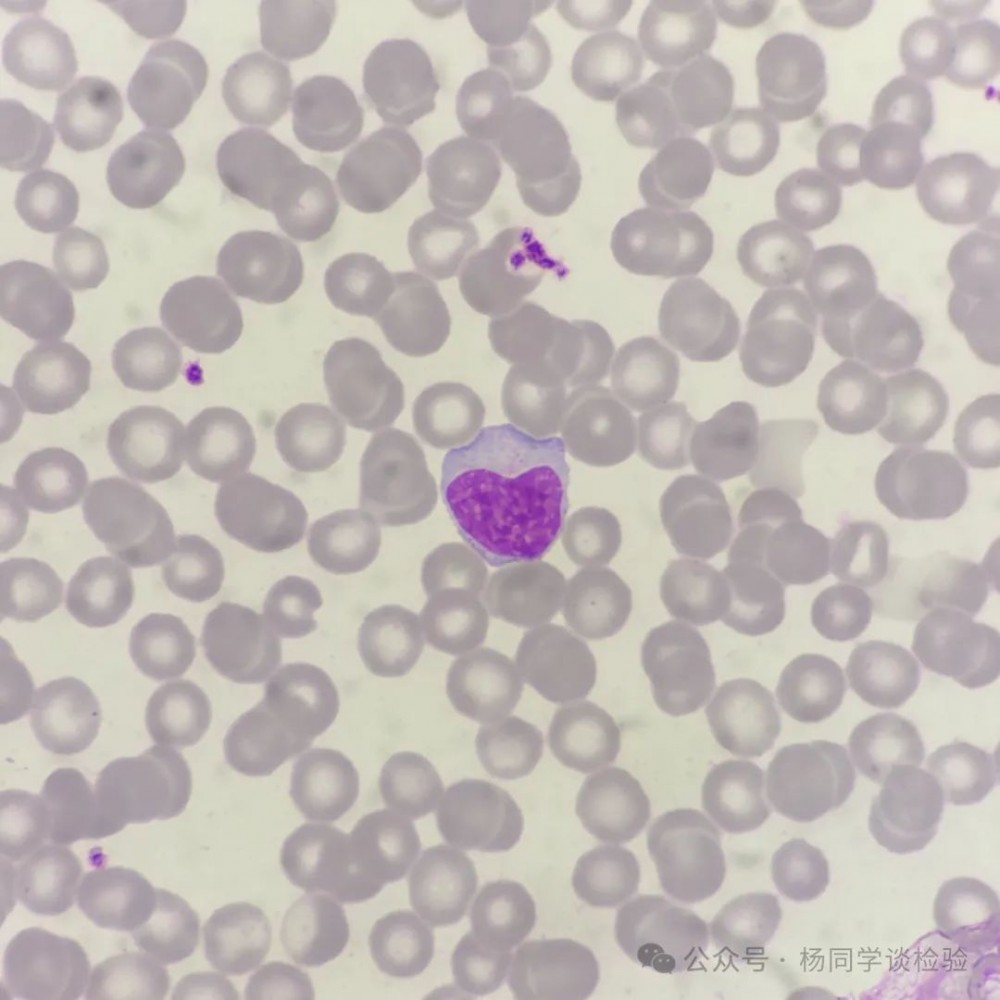
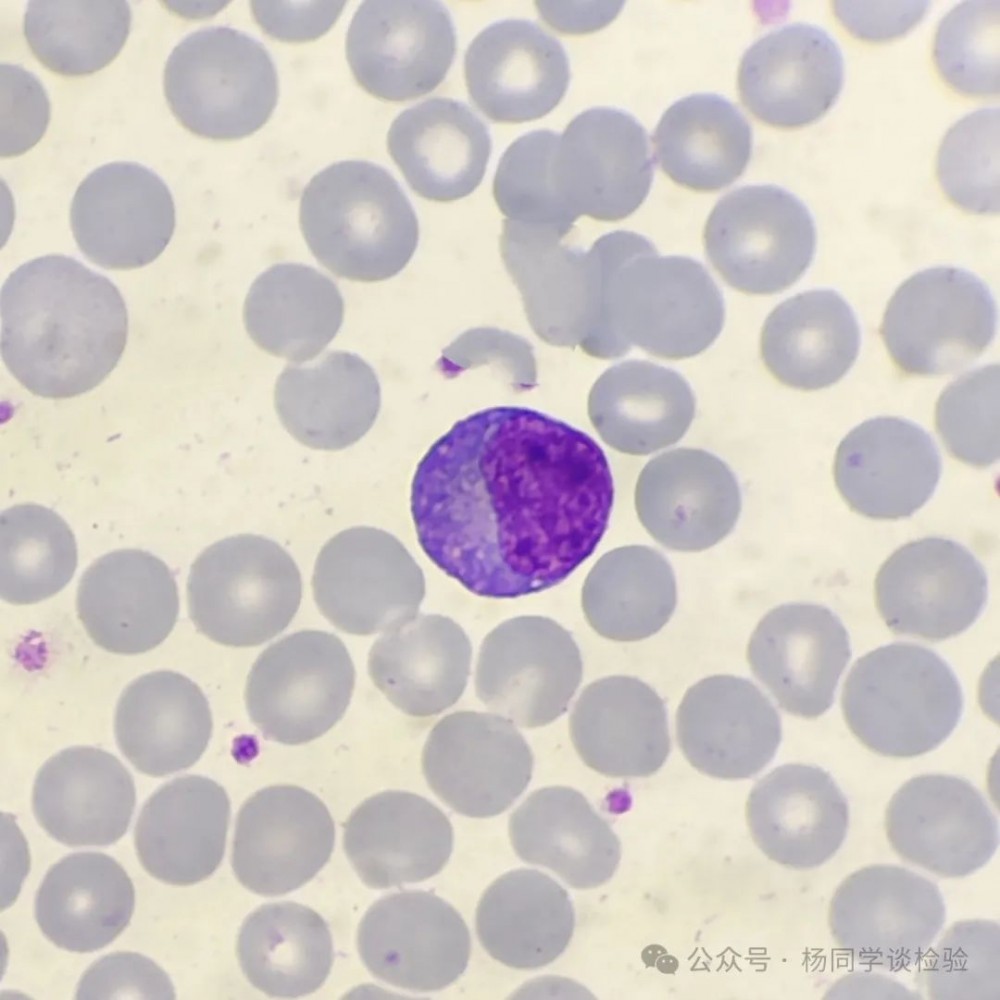

数值正常不代表形态正常
01
声明
细胞形态学主观性非常强,如有不同意见,可忽略本文
异型淋巴细胞主要分为三种类型:
①浆细胞型(空泡型);
②单核细胞型(不规则型);
③幼稚型。
其中浆细胞型和幼稚型特征突出,较好辨认,而单核型异淋常常在某些形态特征与单核细胞存在一定的相似性,因此在区分上存在一些难度。
首先看几位形态学专家对异型淋巴细胞的形态描述。中山市博爱医院黄道连教授:淋巴异淋亲兄弟,异淋因被病毒欺,激活异淋杀病毒,异淋体内藏武器。异型淋巴细胞俗称异淋,特点:体大>4个红细胞,个头不大一票否决!!!核大,浆量多,胞浆深蓝,近核处有苍白区,通常是由病毒(主要的EB病毒)激活淋巴细胞呈现免疫母细胞化,(胞体增大,胞核大且胞浆量多,浆深蓝色,从而产生众多的抗病毒的活性物质如淋巴因子,干扰素等),所以,异淋体内藏有大量的杀病毒武器!异淋胞体增大似怀了孕的母亲。北京大学第一医院王建中教授主编的《临床检验诊断学图谱》中对异淋的描述:根据形态学特点,异型淋巴细胞可分为三型:I型,空泡型或浆细胞型,最常见,胞体圆形,比正常淋巴细胞大,核呈圆形、椭圆形、肾形或不规则形,染色质呈不规则块状排列,有缝隙感;胞质丰富呈深或灰蓝色泡沫状。Ⅱ型,不规则型或单核细胞型,胞体较大,似单核细胞,外形可不规则,常见伪足,核呈圆形或不规则形,着色较I型者稍浅淡,胞质丰富呈浅蓝色或蓝色,有透明感,胞质边缘处着色较深呈裙边状,胞质内常无颗粒~四。Ⅲ型,幼稚型,胞体较大,核圆形或椭圆形,染色质较粗网状,可见1~2个核仁,胞质深蓝色,偶见少量空泡。秦皇岛第一医院陈宏伟教授:异淋体大胞浆蓝,裙角飞扬舞翩翩。体小浆蓝核母化,一型空泡二型单,三型异淋要见全。三型幼稚莫看偏。四五七十一二月,出现高峰慢退减。异淋多见童少年,中老须把淋瘤鉴。核浆高比大淋巴,体巨核畸多恶变。异淋只计一二三,激活淋巴不包含。性质不定报不典,结合临床多察观。
由此可见,各位专家对于异型淋巴细胞的特征有共通点:第一体积增大,第二胞浆变蓝。因此,在这两个特点的前提下,笔者采集了部分形态与异淋有一定相似之处但又达不到异淋标准的淋巴细胞,来与各位老师讨论。
笔者认为,淋巴细胞向异型淋巴细胞转变是一个过程化,如果把正常的淋巴细胞比作起点,那异型淋巴细胞就是终点,而处在中间过程的细胞,可以称之为刺激性淋巴细胞。所谓刺激性淋巴细胞,就是受到病毒、原虫或是药物等相关因素的刺激后,淋巴细胞形态发生了一定的改变,但是又达不到异淋的标准,故称之为刺激性淋巴。
图一

图二

图一、图二中的淋巴细胞,胞浆深蓝,嗜碱性强,但是体积偏小,达不到三种典型异淋的标准,因此归到刺激性淋巴。
图三

图四
此类细胞归类最具有争议性,部分老师认为该细胞体积大,胞浆边缘有深蓝色裙边,因此归到单核型异型淋巴细胞。但是仔细看后,发现该细胞仅仅胞浆边缘发蓝,但是大部分胞浆颜色依旧透亮,没有出现变蓝的情况,因此笔者认为依旧划分到刺激性淋巴。
图五

图六

图五、图六笔者在此归进大颗粒淋巴细胞。图中淋巴细胞体积增大,胞浆中有较为清晰明显的颗粒。大颗粒状淋巴细胞是一类胞质内含大的嗜苯胺颗粒的淋巴细胞。多为NK细胞。也包括效应T细胞等,效应T细胞介导机体的细胞免疫,NK则对肿瘤细胞和病毒感染细胞有杀伤作用。
图七

图八
图七、图八笔者归为单核细胞,部分对于单核细胞形态掌握不牢的老师易将这两个细胞归到异型淋巴细胞中。从胞浆看,图中细胞胞浆呈现出灰蓝或灰红色,内含较多细小的粉尘样颗粒;从染色质来看,染色质疏松呈粗网状,无淋巴细胞染色质的厚重感。综合分析为单核细胞。
图九

图十

图九、图十均为异常淋巴细胞,此类型迷惑性极大。二图中淋巴细胞体积极大,核形不规则,可见较为明显的核仁,形态学表现为淋巴瘤细胞,并且需要流式来确诊。
图十一

图十二

图十一、图十二均为成熟的大淋巴细胞。按照正常的淋巴细胞体积大小,可粗略的分为小淋巴细胞,中淋巴细胞以及大淋巴细胞。图中的淋巴细胞体积大,胞浆干净透亮,形态上无明显的变化,故为大淋巴细胞。
看完了这些误区,再看几张典型的异型淋巴的美图。浆细胞型异淋

单核细胞型异淋


幼稚型异淋


看到最后,相信各位老师已经对异型淋巴细胞有了清晰的认知
内容来源 | 杨同学谈检验
图片来源 | veer、ibaotu
排版 | jinbao
审校 | 金宝

